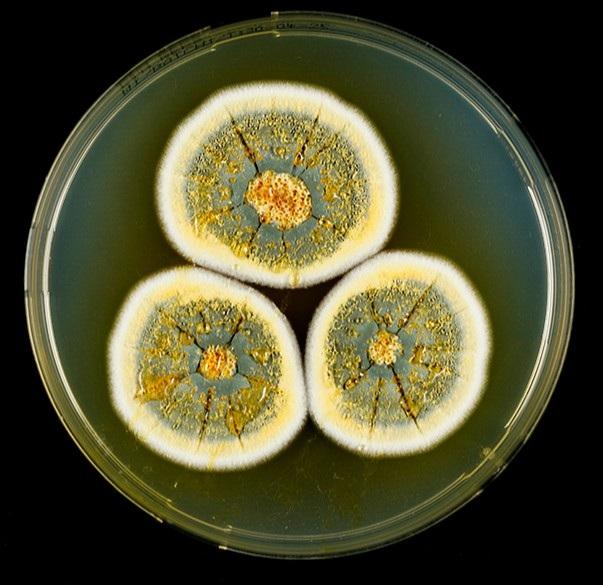
UFLA descobre 12 novas espécies de fungos do Cerrado e da Caatinga com potencial para a bioeconomia

UFLA descobre 12 novas espécies de fungos do Cerrado e da Caatinga com potencial para a bioeconomia
23 de janeiro de 2026 Foto: Divulgação
Foto: Divulgação
Um estudo em desenvolvimento na Universidade Federal de Lavras (UFLA) já identificou doze novas espécies de fungos que habitam os biomas do Cerrado e da Caatinga. Elas estão preservadas a 80°C negativos, na Unidade de Recursos Microbiológicos da UFLA (URMICRO/UFLA), espaço que se torna um verdadeiro banco genético para as futuras gerações. Esses fungos podem vir a ser a base de soluções em áreas como alimentação, medicina, bioinsumos para agricultura e indústria. As descobertas chamam atenção para o fato de que a perda da vegetação nativa nesses biomas pode colocar em risco espécies como essas, ainda desconhecidas, mas com alto potencial para a bioeconomia.
A pesquisa intitulada “Biodiversidade e bioprospecção de Aspergillus ssp, Talamomyces spp. e Penicillium spp. nos domínios florísticos no Estado de Minas Gerais” é liderada pelos professores Luís Roberto Batista, do Departamento de Ciência dos Alimentos da Escola de Ciências Agrárias de Lavras (DCA/Esal/UFLA), e Victor Satler Pylro, do Departamento de Biologia do Instituto de Ciências Naturais (DBI/ICN/UFLA). As amostras de solo foram coletadas em Patrocínio e Jaíba (MG) e levadas ao laboratório da URMICRO/UFLA, onde os fungos são isolados, cultivados, analisados e preservados.
“O foco inicial era descrever a biodiversidade dos microrganismos do solo, mas o potencial biotecnológico deles é enorme”, explica Luís Roberto. Os fungos descobertos podem ser fontes de enzimas industriais, antibióticos e até substâncias usadas na produção de alimentos. É o que os pesquisadores chamam de bioeconomia, baseada no uso sustentável da biodiversidade como motor de inovação e geração de renda.
As doze novas espécies descobertas são dos gêneros Talaromyces, Penicillium e Aspergillus, com predominância do Penicillium. Esses microrganismos são famosos por sua utilidade na medicina e na indústria de alimentos. Algumas delas receberam nomes inspirados em referências regionais, como Penicillium patrocinensis, P. guarae, P. pequii e Penicillium moreirae, homenageando o município mineiro de Patrocínio, elementos da flora local e o trabalho da professora do Departamento de Solos (DCS/UFLA) Fátima Maria de Souza Moreira, que há mais de 30 anos se dedica ao estudo da microbiologia do solo. A pesquisa também homenageia o professor Paulo Sérgio Lacerda Beirão, ex-presidente da Fundação de Amparo à Pesquisa do Estado de Minas Gerais (Fapemig), com a denominação da espécie Penicillium beraoi, reconhecendo sua contribuição histórica para o fomento à ciência em Minas Gerais e no Brasil.
Outro destaque foi a alta produção de quitinase em fungos isolados de solos de café convencional. Essa enzima, capaz de degradar quitina – o mesmo material que compõe o exoesqueleto de insetos e crustáceos – tem amplo uso na agricultura, na medicina e na biotecnologia, podendo substituir processos químicos poluentes na produção de bioinsumos.
Luís Roberto ressalta que o Brasil – por abrigar uma das maiores biodiversidades do planeta – tem todas as condições para liderar a bioeconomia nas próximas décadas. “Os países com maior biodiversidade serão os mais ricos no futuro. E o Brasil está nessa lista, desde que saiba preservar e conhecer o que tem”, pondera. Ele lembra que o Cerrado, por exemplo, é o segundo maior bioma brasileiro e um dos mais ricos em biodiversidade do planeta. Mas já perdeu quase metade de sua vegetação nativa, substituída por lavouras e pastagens. “Essa transformação silenciosa impacta não apenas plantas e animais visíveis, mas também o mundo invisível dos microrganismos do solo, essenciais para a fertilidade e o equilíbrio ecológico”.
Além de contribuir para o conhecimento científico, a pesquisa tem impacto social e ambiental. Em parceria com produtores rurais, a equipe de estudos realizou palestras na região de coleta de amostras, promovendo a valorização da biodiversidade microbiana do solo e a aproximação entre Universidade e comunidade.
Biodiversidade ameaçada
O estudo chama a atenção para o impacto ambiental das queimadas sobre a riqueza invisível, uma vez que os fungos resistem à temperatura de até 60 °C, mas o calor de uma queimada pode ultrapassar essa marca, destruindo espécies que nem sequer chegaram a ser conhecidas pela ciência. “A biodiversidade de microrganismos pode ser até maior do que a de plantas e a gente ainda sabe muito pouco sobre ela”, ressalta Batista.
O professor Victor Pylro reforça que o grande desafio está em transformar esse patrimônio natural em inovação e desenvolvimento sustentável. “O uso racional da biodiversidade brasileira passa, necessariamente, pela capacidade de converter um enorme acervo genético em soluções biotecnológicas que gerem valor econômico, social e ambiental”, afirma. Nesse contexto, a preservação em coleções científicas como a URMICRO/UFLA se consolida como um verdadeiro investimento estratégico para o futuro, assegurando que esses recursos permaneçam acessíveis às próximas gerações de pesquisadores.
Colaboração internacional
As limitações técnicas para o sequenciamento genético no Brasil levaram a equipe a buscar uma parceria internacional com o Westerdijk Fungal Biodiversity Institute, em Utrecht, na Holanda. Alguns estudantes, como os doutorandos Harisson Guimarães de Souza e Cristiane Nascimento Figueiredo, realizaram parte da pesquisa na instituição holandesa, onde desenvolveram a etapa molecular das análises. A colaboração obtém resultados significativos.
Com o uso de técnicas modernas de Sequenciamento de Nova Geração (NGS) e análises taxonômicas avançadas, o estudo identificou 1.481 fungos em amostras de solo de três tipos de áreas: Cerrado nativo, cultivo de café convencional e cultivo de café regenerativo – este último voltado à recuperação da saúde do solo e à sustentabilidade.
A equipe agora investiga o potencial biotecnológico desses novos fungos. “Esses fungos podem ajudar a transformar celulose em açúcar, por exemplo, o que abre caminhos para novas formas de energia limpa”, explica Luís Roberto. Segundo a doutoranda Cristiane, cada nova espécie descrita amplia as possibilidades de uso sustentável dos recursos naturais do Cerrado, “ao mesmo tempo em que reforça a urgência de preservá-lo”.
As iniciativas contam com financiamento de agências estratégicas, como a Financiadora de Estudos e Projetos (Finep), a Fundação de Amparo à Pesquisa do Estado de Minas (Fapemig), Conselho Nacional de Desenvolvimento Científico e Tecnológico (CNPq) e a Coordenação de Aperfeiçoamento de Pessoal de Nível Superior (Capes). O trabalho também está alinhado a diversos Objetivos de Desenvolvimento Sustentável (ODS) da ONU, como agricultura sustentável, consumo responsável e ação contra a mudança do clima.





